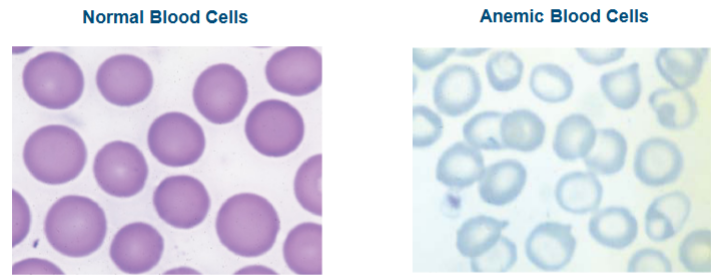

Minerals
Major minerals - amounts > 100 mg/day
Calcium, phosphorus, potassium, sulfur, sodium, chloride, magnesium
Trace minerals - amounts <mg/day
Iron, zinc, copper, manganese, iodine, selenium
Shortfall nutrients:
Calcium, potassium, magnesium, and iron
Overconsumed:
Sodium
Major Minerals:
The need for each of these is greater than 100 mg/day in some cases far greater
Calcium
Chloride
Magnesium
Phosphorus
Potassium
Sodium
Sulfate
The major minerals are also called microminerals
Calcium:
Most abundant mineral in the boy
Critical to body functioning
Storate facilities- 99% in bone and teeth
Bones
Big part of bone structure
bone calcium serves as a bank that can release calcium to the body fluids if a drop in blood calcium
Formation and dissolution takes place every minute

Teeth: Bone and tooth formation
Hydroxyapatite: the chief crystal of bone and teeth, formed from calcium and phosphorus
Bone: Hydroxyapatite crystals invades collagen
Teeth: Hydroxyapatite forms on collagen to create dentin that gives strength to teeth
One % of the body’s calcium is in the fluids.
Roles:
Regulates the transport of ions across cell membrane
Helps maintain normal blood pressure
Essential in the clotting of blood
Essential for muscle contraction (heartbeat)
Activates cellular enzymes
Blood calcium is tightly controlled
Calcium balance:
Intestines, kidneys and bones assist with calcium balance
Skeleton serves as calcium bank
Bone density: a measure of bone strength, the degree of mineralization of the bone matrix
Calcium absorption
Increase in times of need
Times of increased absorption:
Bone loss:
Peak bone mass
Highest bone density attained by an individual; developed during the first three decades of life
Inevitable consequence of aging
Insufficient calcium savings cause:
Osteopenia: a condition of low bone mass that often progresses to osteoporosis
Osteoporosis: Reduction of the bone mass of older people in which the bones become porous and fragile
Osteoporosis:
Osteoporosis prevalence:
10 million have disease
80% are women
Fractures
Gender, age, genetics and physical activity
Develops silently over years.
Development of Osteoporosis:
Bone:
Trabecular: Weblike structure composed of calcium-containing crystals inside a bones solid outer shell wall. Provides strength and acts like a calcium storage bank. Tapped to raise blood calcium
Bone loss:
Dowager’s hump
Fractures: Hip and spine are common sites


Nutrients and Bone Health:
Calcium and vitamin D
Bone strength in later life
Bone building during childhood and adolescence
You can’t build any more bone after 30.
Protein
Improves bone status and reduces the incidence of hip fractures
Nutrients important to bones
Vitamins K, A, and C
Magnesium and omega-3 fatty acids



Phosphorus:
Second most abundant mineral in the body
Majority found in bones and teeth
Roles in the body
Phosphorus salts are critical buffers, helping to maintain the acid-base balance of cellular fluids
Essential for growth and renewal of tissues due to being a part of DNA and RNA of every cell
Involved in metabolism of energy nutrients
Phosphorus compounds act as cofactors, assisting many enzymes in extracting energy from nutrients
Phosphorus forms part of the molecules of the phospholipids that are the principal components of cell membranes
Present in some proteins
Deficiencies are unlikely
Excess phosphorus in the blood.
Indicators of heart and kidney diseases.

Magnesium:
Major mineral as it is a dietary requirement
Over half of it is in the bones
The rest is in the muscles, heart, liver, other soft tissues, and body fluid
Roles in the body:
Cofactor for hundreds of enzymes
Needed for the release and use of energy from the energy-yielding nutrients
Part of the cellular protein-making machinery.
Critical to nerve transmission, muscle contraction, and heart function
Works with calcium for proper functioning of the muscles
Deficiency:
Chronic: Causes diabetes, heart failure, hypertension, inflammation, and stroke
Acute: May occur with alcoholism, prolonged diarrhea, vomiting, or severe malnutrition.
Toxicity:
Symptoms include diarrhea, acid-base imbalance, and dehydration

Sodium:
Principal positively charged ion in outside cells
Roles:
Major part of fluid and electrolyte balance
It is the chief ion used to maintain the volume of fluid outside cells
Helps maintain acid-base balance
Essential for muscle contraction and nerve transmission
Deficiency:
Results in hyponatremia: The condition of having too little sodium in the blood
Recommendations:
DRI: 1500 mg for healthy, active young adults; 1300 for 51-70 years of age, 1200 mg for elderly

UL: 2300 mg/day adults
Dietary guidelines for Americans 2015-2020
consume less than 2300 per day of sodium
further, reductions to 1500 of sodium may produce greater benefits to people with hypertension or prehypertension
Blood pressure: High sodium intake correlates with hypertension, heart disease, aggrevated kidney problems, and stroke.
Dietary approaches to stop hypertension (DASH) diet
Increased potassium-rich fruits and vegetables
Adequate amounts of nuts
Fish
Whole grains
Low-fat dairy products
Controlling salt intakes
Cut down processed and fast foods
Potassium:
Principal positively charged ion inside cells:
Roles
Fluid and electrolyte balance
Cell integrity
During nerve impulse transmission and muscle contraction, potassium and sodium trade places briefly across the cell membrane. The cell the pumps bac into place
Heartbeat
Deficiency: Dehydration, heart failure
Toxicity: can stop the heart when injected into a vein
Chloride:
Chloride ion is the major negative ion
Roles:
Helps maintain fluid balance
Maintains acidity of the stomach, necessary for protein digestion
Food source: Salt
Sulfate:
Roles
important in helping strands of protein assume their functional shapes
NO recommended intake
Deficiencies unknown
Toxicity
causes diarrhea and may damage the colon
Trace Minerals:
These minerals are needed by the body in tiny amounts
Iodine
Iron
zinc
Selenium
Fluoride
Chromium
copper
Manganese
Molybdenum
Also called microminerals
Iodine:
Body’s work is done by ionic form iodide
Roles:
Cofactor that works with the hormone thyroxine, made by the thyroid gland
Thyroxine regulates:
The body’s metabolic rate, temperature, reproduction, growth, and heart functioning
Deficiency:
Goiter: Enlargement of the thyroid gland, Enlargement due to iodine excess is toxic goiter
Cretinism: Severe mental and physical retardation of an infant caused by the mother’s iodine deficiency during pregnancy.
Toxicity:
Enlarged thyroid gland
Poisonous in large amounts
Food sources
Seafood, salt, and vegetables grown in iodine-rich soil


Iron:
Every living cell contains iron
A compound of two proteins
Hemoglobin: The oxygen-carrying protein of the blood; found in the red blood cells, carries oxygen from the lungs and to tissues throughout the body
Myoglobin: The oxygen-holding protein of the muscles
Roles:
Carries oxygen
Makes new cells, amino acids, hormones, and neurotransmitters.
Part of the enzymes involved in energy metabolism
Iron stores:
Iron from red blood cells recycled and stored in bone marrow
Special proteins transport and store iron
Hepcidin regulates blood iron levels
Absorption of iron
Heme: Iron containing part of hemoglobin and myoglobin from meat, poultry, and fish.
Nonheme iron: From plants and meat
Vitamin C and MPF factor promote absorption
Impaired by tannins (compounds in tea and coffee that bind iron)
and phytates (compounds present in plant foods (whole grains) that bind iron and may prevent its absorption)
Promotors and Inhibitors of Iron Absorption:
These dietary factors increase iron absorption
Heme form of iron
Vitamin C
Meat, fish, poultry (MFP) factor
These dietary factors hinder iron absorption
Nonheme form of iron
Tea and coffee
Calcium and phosphorus
Phytates, tannins, and fiber
Iron Deficiency:
Iron-deficiency anemia:
A form of anemia caused by a lack of iron and characterized by red blood cell shrinkage and color loss.
Distinction between iron deficiency and its anemia is a matter of degree.
May be iron deficient (depleted iron stores) without being anemic. With worsening iron deficiency, they may become anemic.
Anemia: Condition of inadequate or impaired RBC’s; a reduced number of volume of RBC along with too little hemoglobin in the blood.
Signs of deficiency:
Fatigue, apathy, and a tendency to feel cold.
Children become restless, irritable, unwilling to work or play
Pica: A craving and intentional consumption of nonfood substances
Ice, chalk, starch, clay, soil, and other nonfood substances.
Causes of Iron Deficiency and Anemia:
Inadequate iron intake
Blood loss
Groups most susceptible to deficiency
Women in reproductive years and pregnant women
Infants, toddlers, adolescents, and obese individuals.
Too Much Iron:
Toxicity:
May promote cancers of the colon and rectum
Damages to liver, joints, or heart
Susceptibility to infections
Can harm the immune system
Poisoning can be fatal in young children
Symptoms:
Fatigue, mental depression, or abdominal pain.

Zinc:
Present in every organ
Roles - Cofactor form more than 300 enzymes to:
Protects cell structures against damage from oxidation
Makes parts of cells genetic material
Makes the heme of hemoglobin
Assists the pancreas with its digestive and insulin functions and helps metabolize carbohydrate, protein, and fat
Special zinc-containing proteins associate with DNA and help regulate protein synthesis and cell division
Functions critical to normal growth before and after birth.
Needed to produce the active form of Vitamin A in visual pigments
Zinc also:
Affects behavior, learning, and mood
Assists in proper immune functioning
Essential to wound healing, sperm production, taste perception, normal metabolic rate, nerve and brain functioning, bone growth, and normal development in children.
Groups at risk of deficiency:
Pregnant women, young children, the elderly, and the poor
Excess zinc:
Causes vomiting, diarrhea, headaches, and exhaustion
Inhibits iron absorption from the digestive tract

Selenium:
Roles in the body:
Works as a cofactor
Limits the formation of free radicals
Prevents oxidative harm to cells and tissues
Deficiency:
Muscle disorders with weakness and pain
Increases the risk of heart disease and cancer
Toxicity:
Due to supplements:
Hair loss, brittle nails
Diarrhea and fatigue
Bone, joint, and nerve abnormalities
Sources: Meat and shellfish
Fluoride:
Roles in the body:
Fluorapatite improves resistance of bones and teeth to demineralization
Deficiency:
Dental decay
Toxicity:
Fluorosis: Discoloration of the teeth due to ingestion of too much fluoride during tooth development
Sources: Water
Chromium:
Participates in carbohydrate and lipid metabolism
Roles: Regulates blood glucose
Sources: Unrefined foods
Toxicity: Industrial chromium: a carcinogen that damages DNA
Copper:
Helps form hemoglobin and collagen
Deficiency:
Disturbs growth and metabolism in children
Impairs immunity and blood flow through the arteries in adults
Food sources: Organ meats, seafood, nuts, and seeds
Other trace minerals and some candidates:
Molybdenum
Manganese
Boron
Cobalt
Nickel
Others
All trace minerals are toxic in excess
UL’s exist for boron, nickel, and vanadium
